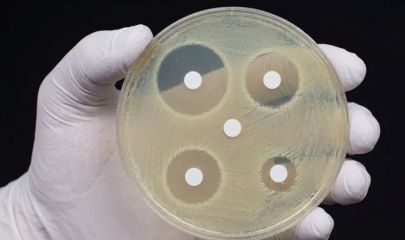

L’Antibiogramme : tout ce qu’il faut savoir pour un traitement efficace !

L’antibiogramme est un examen de biologie médicale utilisé pour adapter le traitement des infections bactériennes documentées. Très courant en laboratoire, il permet de déterminer avec précision la sensibilité d’une bactérie face à différents antibiotiques. Cet examen permet de limiter l’échec thérapeuthique et participe à la stratégie de bon usage des antibiotiques visant à limiter l’antibiorésistance.
Dans certaines infections, notamment urinaires ou sévères, l’antibiogramme oriente le médecin vers le meilleur choix de molécule. Cet article vous présente en détail le fonctionnement de l’antibiogramme, les étapes du diagnostic, ainsi que les clés pour bien comprendre vos résultats.
Le rôle central de l’antibiogramme dans la lutte contre l’infection
Son objectif est de mesurer la capacité d’un antibiotique à stopper la prolifération d’une bactérie identifiée chez un patient.
En identifiant précisément les molécules efficaces, le biologiste permet au médecin de prescrire le traitement le plus précis et efficace possible. Cette approche, appelée épargne antibiotique, est essentielle : elle permet de traiter l’infection out en limitant l’impact sur votre microbiote. Par ailleurs, elle contribue, à l’échelle collective, à réduire la sélection et la diffusion de bactéries résistantes.
De l’échantillon au germe identifié : les étapes du processus
La réalisation d’un antibiogramme suit un protocole rigoureux en plusieurs phases, allant du prélèvement à l’analyse technique.
Le prélèvement biologique : première étape du diagnostic
Tout commence par la collecte d’un échantillon biologique au niveau du site infecté :
- Urines (ECBU) pour les infections urinaires.
- Prélèvement cutané
- Prélèvement vaginal.
- Sang (hémocultures) en cas de suspicion de sepsis.

L’ensemencement et la culture bactérienne
Le prélèvement est déposé sur des milieux de culture spécifiques (géloses) pour favoriser la croissance des germes. Ce processus prend généralement 24 à 48 heures, mais peut s’étendre à plusieurs jours pour certaines bactéries plus lentes à pousser.
L’identification par spectrométrie de masse
Une fois la bactérie cultivée, le laboratoire utilise des technologies de pointe comme le MALDI-TOF pour mettre un nom précis sur l’agent pathogène en quelques minutes seulement.
Interpréter la réponse de la bactérie : décoder les résultats S, I et R
Les résultats de l’antibiogramme sont classés selon des normes internationales (EUCAST). Depuis 2019, ces catégories sont directement liées à la dose d’antibiotique nécessaire pour atteindre le site de l’infection.
- S (Sensible à exposition standard) : La bactérie est éliminée avec une posologie standard. Le succès du traitement est très probable.
- I (Sensible à exposition augmentée) : le succès du traitement est probable si l’exposition à l’antibiotique est augmentée. Cela peut signifier une dose plus forte, des prises plus fréquentes ou une administration par voie intraveineuse.
- R (Résistant) : forte probabilité d’échec thérapeutique, même en cas d’exposition élevée à l’antibiotique.
Comprendre votre compte rendu : l’expertise du biologiste
Il arrive que le compte rendu de laboratoire ne liste pas tous les antibiotiques existants. C’est une démarche volontaire et sécurisée.
Le rendu sélectif des résultats d’antibiogramme
Le laboratoire pratique souvent un rendu sélectif. Au lieu de fournir une liste exhaustive, le biologiste sélectionne les molécules les plus adaptées au germe identifié et au site infectieux . L’objectif est de guider le médecin vers le traitement optimal.

Pourquoi des antibiotiques sont-ils « masqués » sur l’analyse ?
Certains antibiotiques peuvent ne pas apparaître dans les résultats d’un antibiogramme. Cette pratique s’inscrit dans une démarche encadrée en microbiologie clinique, visant à orienter le choix thérapeutique vers les options les plus adaptées. Lorsqu’une bactérie est sensible à plusieurs antibiotiques, les biologistes privilégient en première intention des molécules à spectre étroit, c’est-à-dire actives sur un nombre limité de bactéries, plutôt que des antibiotiques à large spectre qui agissent sur un plus grand nombre de micro-organismes. Ce choix repose sur une logique de bon usage des antibiotiques. L’exposition à des molécules à large spectre peut favoriser la survenue d’effets indésirables et contribue au développement de résistances bactériennes, phénomène par lequel certaines bactéries deviennent moins sensibles aux traitements. Ainsi, les antibiotiques dits « masqués » restent généralement actifs contre la bactérie identifiée, mais leur affichage est volontairement limité afin de préserver leur efficacité et de favoriser des prescriptions plus ciblées.
Qu’est-ce qu’un antibiogramme ciblé ?
L’antibiogramme ciblé consiste à ne tester que les familles d’antibiotiques réellement pertinentes pour la bactérie identifiée. C’est une analyse sur mesure qui garantit une prise en charge personnalisée.
Consulter un professionnel de santé
Il est important de consulter un médecin pour toute interprétation d’un antibiogramme et de suivre ses recommandations. N’hésitez pas à prendre rendez-vous avec un professionnel de santé.
